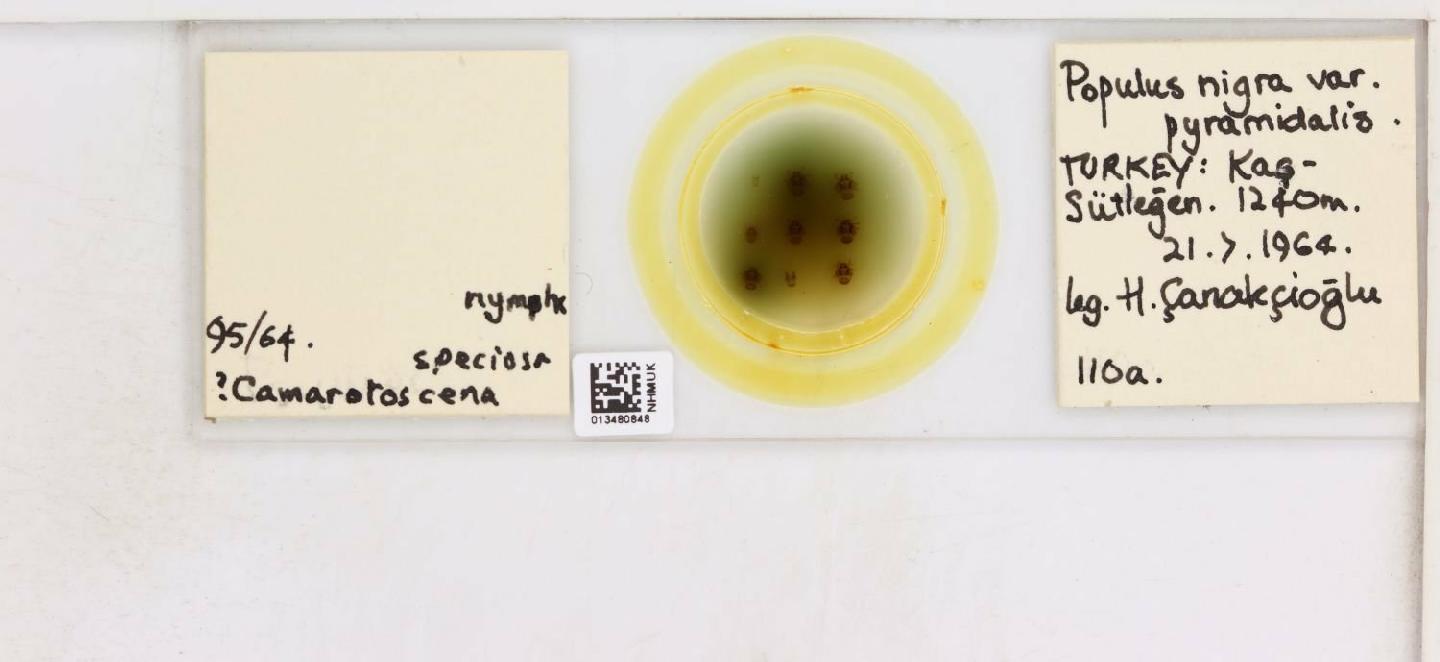

Espèces 2513 à 2528 sur 2929
Cacopsylla sorbi
Linnaeus, 1767
73 occurrences
73 medias

Cacopsylla ulmi
Foerster, 1848
56 occurrences
56 medias

Cacopsylla viburni
Löw, 1876
5 occurrences
5 medias

Cacopsylla visci
Curtis, 1835
48 occurrences
48 medias

Cacopsylla zetterstedti
Thomson, 1877
61 occurrences
61 medias

Camarotoscena speciosa
Flor, 1861
101 occurrences
101 medias
Chamaepsylla hartigii
Flor, 1861
54 occurrences
54 medias

Colposcenia aliena
Löw, 1881
25 occurrences
25 medias

Colposcenia faceta
Loginova, 1960
6 occurrences
6 medias

Colposcenia tamaricis
Puton, 1871
3 occurrences
3 medias

Craspedolepta artemisiae
Foerster, 1848
7 occurrences
7 medias

Craspedolepta flavipennis
Foerster, 1848
4 occurrences
4 medias

Craspedolepta malachitica
Dahlbom, 1851
5 occurrences
5 medias

Craspedolepta nebulosa
Zetterstedt, 1828
73 occurrences
73 medias

Craspedolepta nervosa
Foerster, 1848
25 occurrences
25 medias

Craspedolepta pilosa
Oshanin, 1870
8 occurrences
8 medias
